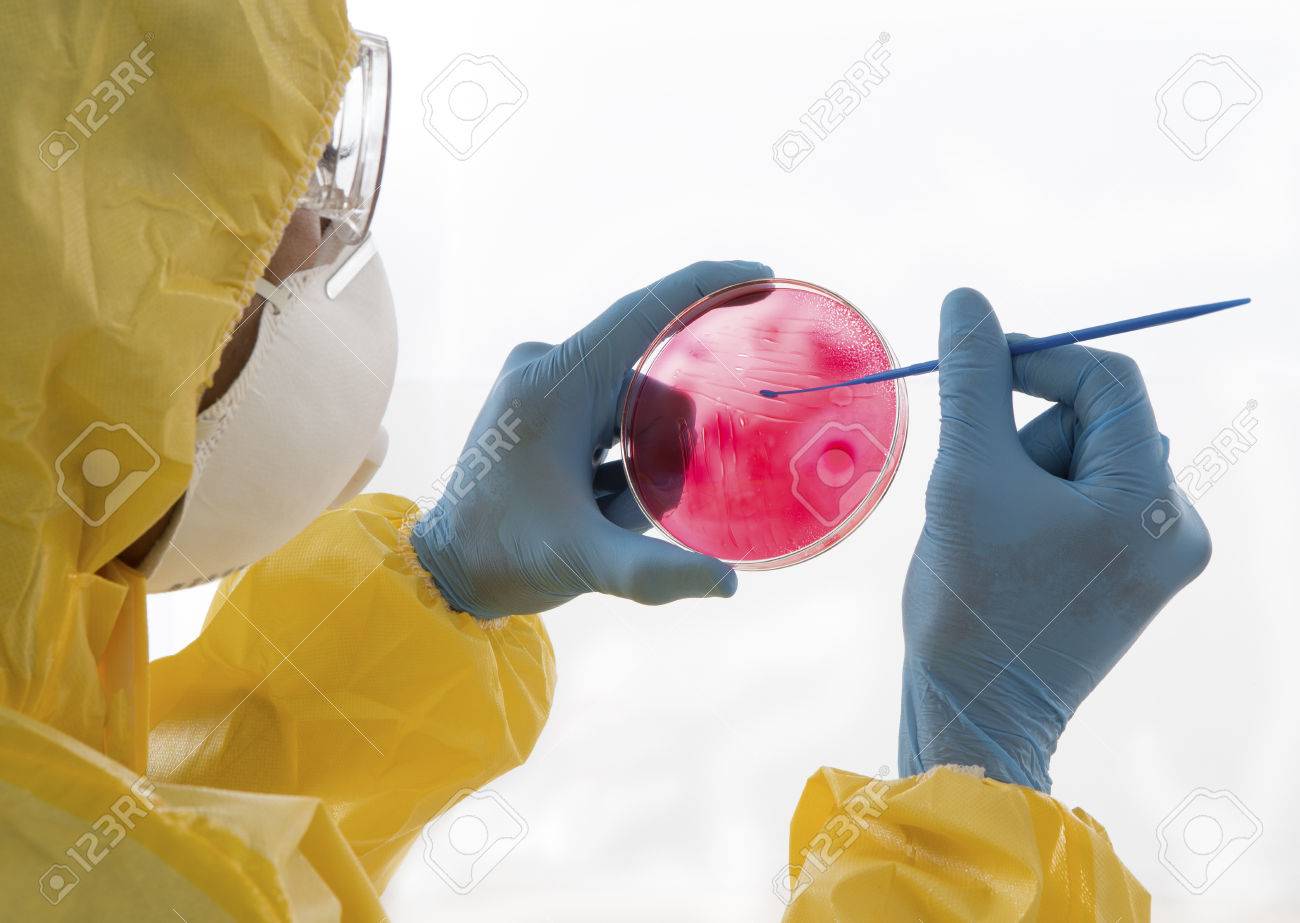
etiam-dictum-ipsum-a-felis

Download
Close
Автор:
id:
Ключевые слова:
19 to 25 year old, adult, african, alone, american, analysis, close up, comparison, concentration, examination, eyeglasses, gas, glove, holding, hospital, human, hygiene, inoculation, interior, laboratory, laboratory equipment, laboratory technician, look at, man, masculine, mask, medical examination, medicine, microbiology, mulatto, nbc suit, people, petri dish, prevention, protection, protective eyewear, research, researcher, science, virology, virus, young,





